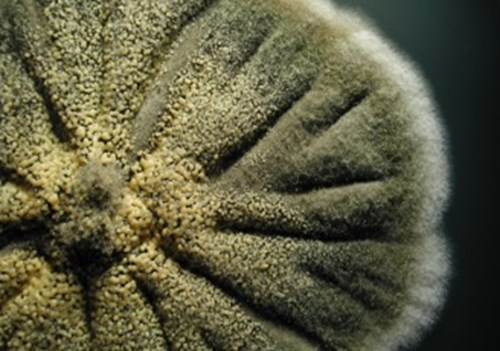

NCPF in research: Phaeohyphomycosis cyst associated with Medicopsis romeroi infection
Phaeohyphomycosis is the term given to deep tissue infections caused by melanised fungi. Typically these infections are caused by fungal species such as Exophiala, Alternaria, Cladophialophora, Phialophora or Curvularia/Bipolaris species; however, other species, including Medicopsis species, have also been implicated. Medicopsis romeroi was previously known as Pyrenochaeta romeroi so many of the earlier case reports will be under this name. Subcutaneous phaeohyphomycoses specifically refers to infection of the deep dermis; this case study reports the occurrence of an infection of the hand, caused by Medicopsis romeroi, following the insertion of an intravenous cannula.
Case report
An 88 year old man presented with a keratotic, horn-like lesion on his right hand one month after the site had been used for insertion of a cannula. The patient had been treated for sarcoidosis, a rare condition which results in granuloma formation in the skin and internal organs. The immunosuppressant drug prednisone had been administered through the cannula. M. romeroi was isolated and confirmed by sequencing and evidence of deep mycosis was confirmed through the histopathological investigations. The organism exhibited susceptibility to several antifungal agents in vitro and the patient was successfully treated.
Colony of M. romeroi on glucose peptone agar
M. romeroi is also known to cause black-grain eumycetoma in which short branching fungal hyphae and chlamydospores form a concretion with a cement-like substance and often invoke a strong pyogranulomatous inflammatory response in the subcutaneous tissue of the affected limb. This case report is consistent with other recent reports of the isolation of M. romeroi from deep, non-mycetoma infections in which the histological appearance is of branching, darkly pigmented hyphae growing through the tissues rather than in grains. Infections have primarily been seen in immunocompromised patients highlighting M. romeroi as an emerging pathogen in this patient group.
NCPF strains
NCPF holds several strains of M. romeroi including the isolate associated with this case:
Catalogue Number |
Name |
Description |
---|---|---|
M. romeroi (Pyrenochaeta romeroi) |
Type strain |
|
NCPF 7881* |
M. romeroi |
Isolate from case above |
*contact us for more information